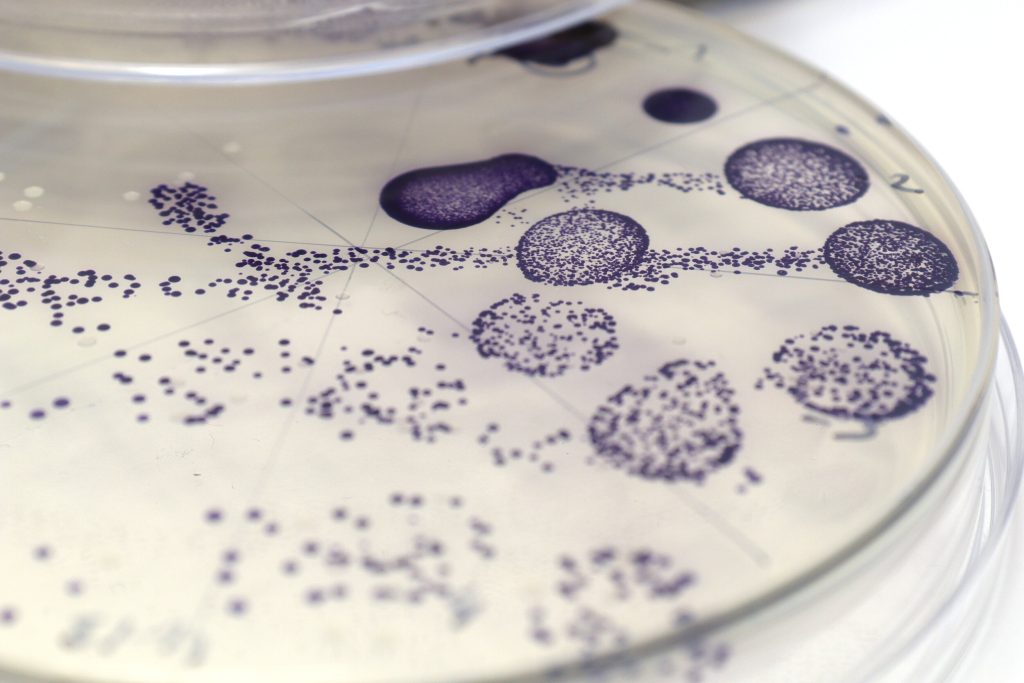
sürdürülebilir tekstil

Moda endüstrisindeki tekstil boyama süreci, çevreye zarar veren toksik kimyasalların kullanımıyla sık sık eleştiriliyor. Ancak İngiliz şirketi Colorifix, bu soruna çözüm sunmak için bakterileri kullanarak bir adım atmış durumda.
2016 yılında kurulan Colorifix, genetik mühendislikle belirli renk yapıcı enzimler üreten bakterileri ticari ölçekte kullanmaya başlayan ilk şirketlerden biri olarak dikkat çekiyor. Şirket, indigo, mor, pastel ve bej gibi çeşitli pigmentleri pazara sunarak sentetik boyaların yerine geçebilecek çözümler sunuyor.
Şirketin kurucuları Orr Yarkoni ve Jim Ajioka, kırsal Nepal’de ağır metal kirliliğini izlemek için yola çıktıklarında tekstil boyama endüstrisinin bu kirliliğe sebep olduğunu keşfettiler. Bunun üzerine sentetik boyaların toksik olmayan bir alternatifini geliştirmek için bakterilerle renk üretme fikri ortaya çıktı.
Colorifix’in temsilcisi Jim Ajioka, “Bakteriler aracılığıyla renk üretebileceğimizi biliyorduk. Asıl mesele, bu renkleri tekstillere aktarmak ve biyolojiyi kullanarak bu süreci verimli hale getirmekti,” şeklinde açıklamalarda bulundu.
Şirket, bakterileri doğal olarak renk oluşturan enzimleri üreten bitkilerin ve hayvanların DNA veritabanıyla modifiye ediyor. Bu modifiye edilmiş bakteriler sıvı kültürlerinde çoğalarak ardından standart boyama makinelerine aktarılıyor. Bu süreçte bakteriler, yüzeye yapışma eğilimleri sayesinde kumaşa eşit bir renk dağılımı sağlıyor.
Colorifix’in süreci, geleneksel boyama süreçlerine göre %80 daha az kimyasal, %77 daha az su kullanımı ve %31 daha az karbondioksit emisyonu sağlıyor.
Şirketin şu ana kadar yedi farklı pigmenti bulunuyor ve bu pigmentlerin bazıları çeşitli renkleri üretebilmek için fermantasyon veya boyama süreçlerinde ayarlamalara olanak tanıyor.
Colorifix, şu anda Avrupa’da üç farklı boyahanesine lisans veriyor ve bu boyahaneler de moda markalarına çevre dostu ve yenilikçi boyama çözümleri sunuyor.
Ancak, Colorifix’in temsilcisi Ajioka, şirketin inovasyonlarının moda endüstrisini tamamen çevre dostu hale getirmeyeceğini vurgulayarak, “Teknoloji tek başına bu sorunu çözmeyecek. Daha düşünceli giyinmeye, kıyafetlerimizin ömrünü uzatmaya ve nihayetinde daha az tüketmeye doğru bir kültürel değişime ihtiyacımız var,” dedi.
Colorifix, sürdürülebilirlik ve çevre dostu teknolojiler alanında gösterdiği başarıyla Dezeen Ödülleri’nde malzeme inovasyonu kategorisinde aday gösterildi.
Bakterilerle yapılan boyama süreci, moda dünyasında sürdürülebilirlik konusunda yapılan diğer yenilikçi adımlarla birlikte sektörde dikkat çeken bir gelişme olarak ön plana çıkıyor.
Kaynak: Dezeen